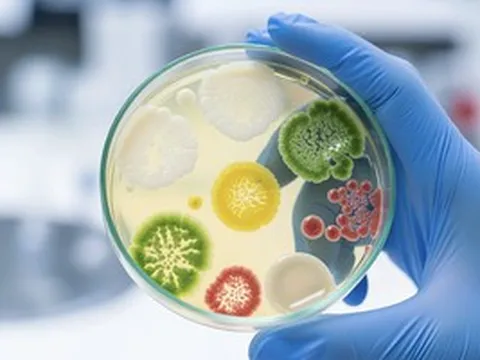
Đang ngồi học, bé 11 tuổi co giật, ngất xỉu do hậu nhiễm liên cầu khuẩn

Chiều 15-4, Bệnh viện đa khoa Bình Chánh (TPHCM) báo cáo Sở Y tế và Sở An toàn thực phẩm TPHCM về việc 11 bệnh nhân là công nhân Công ty TNHH B. (xã Hưng Long) đi cấp cứu sau bữa ăn trưa.

Công nhân ngộ độc thực phẩm sau bữa ăn trưa với cá biển (Ảnh bệnh viện)
Bệnh sử ghi nhận, các công nhân ăn trưa tại công ty gồm cơm và cá biển chế biến sẵn. Sau 1 - 2 giờ, các công nhân cảm thấy khó chịu, bứt rứt, mặt đỏ và nóng bừng, thở mệt, nổi nốt hồng ban ở tay và ngực. Có người kèm đau bụng, ói, nhiều lần tiêu lỏng.
Trước đó, các công nhân đến bệnh viện cấp cứu từ 14 - 15 giờ ngày 14-4. Sau khi được xử trí cấp cứu, có 6 bệnh nhân xuất viện, 5 bệnh nhân cần nhập viện theo dõi, tình trạng ổn. Đến chiều 15-4, bệnh viện cho biết các ca bệnh đều đã xuất viện.
Tất cả các bệnh nhân được chẩn đoán phản vệ độ 1 nghĩ đến do thức ăn. Có bệnh nhân được chẩn đoán bị tổn thương thận cấp; theo dõi ngộ độc thực phẩm.